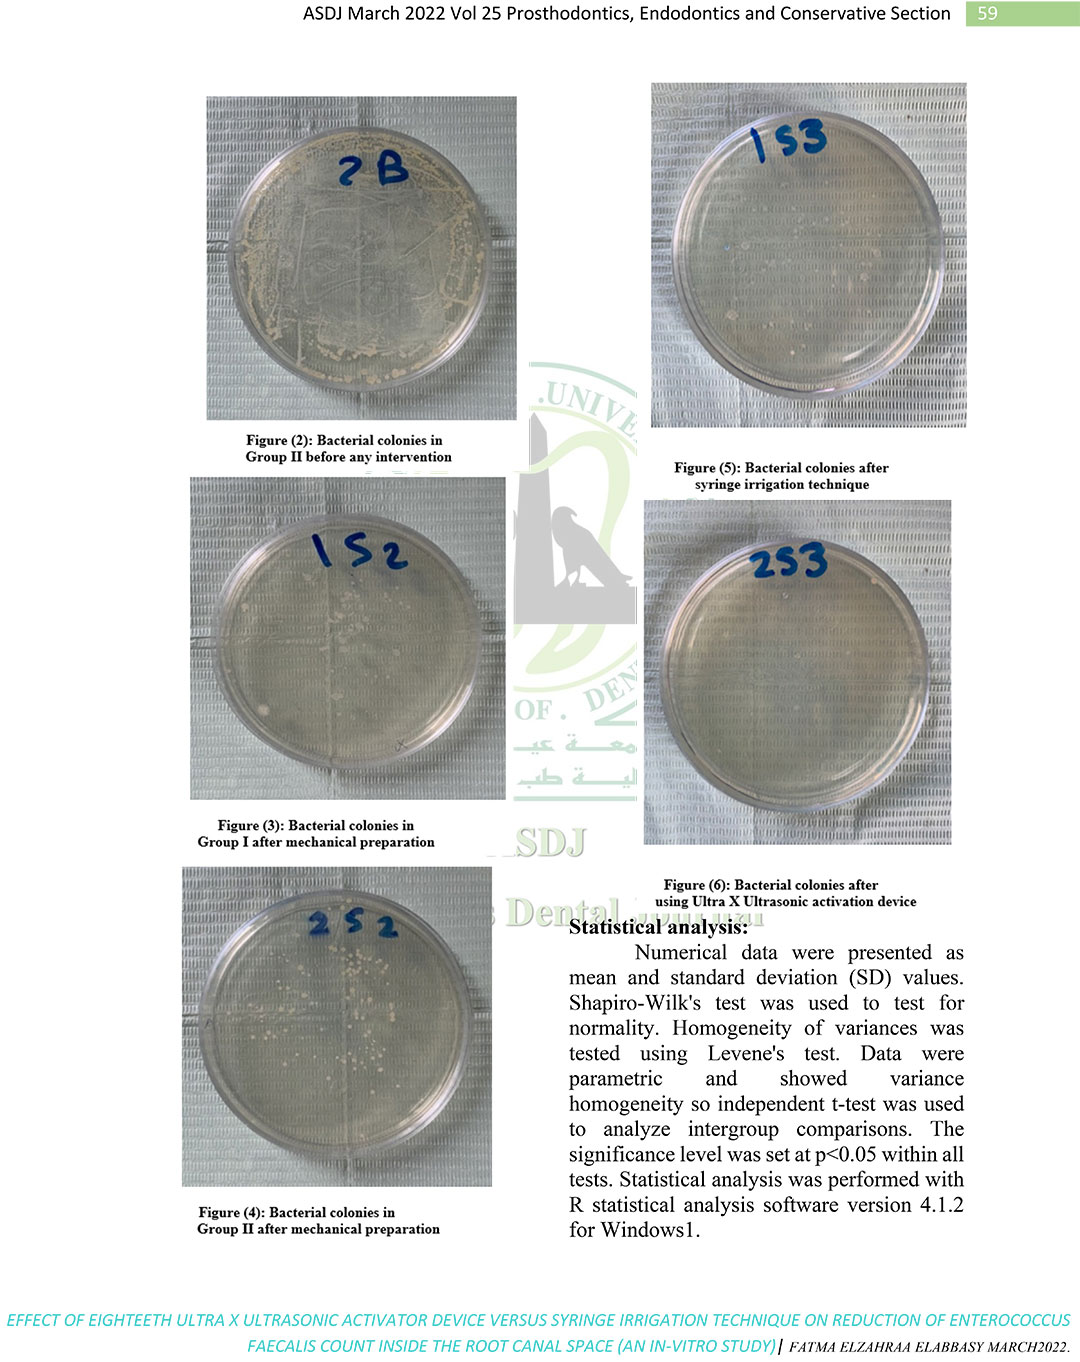
4_1

Disclaimer: The third-party literature content referenced in this article is provided solely for the purposes of academic exchange and information sharing. It does not represent our position or endorsement of any technical parameter comparisons (if applicable) mentioned herein. The related data and conclusions are derived from independent research, and we shall not be held liable for the objectivity or accuracy of such content under any legal jurisdiction.